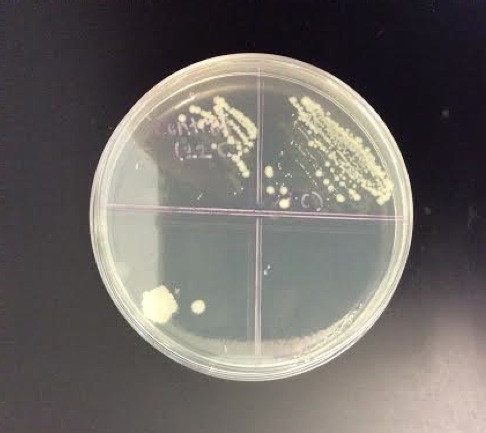

Sign up for FlowVella
Sign up with FacebookAlready have an account? Sign in now
By registering you are agreeing to our
Terms of Service
Loading Flow

# of colonies: 259
# of colonies: 78
37C, T1
37C, T2
37C, T3
# of colonies: 193
Results: The Effect of 37C on Bacteria Growth
x
x
x

x
x
Average # of colonies: 176